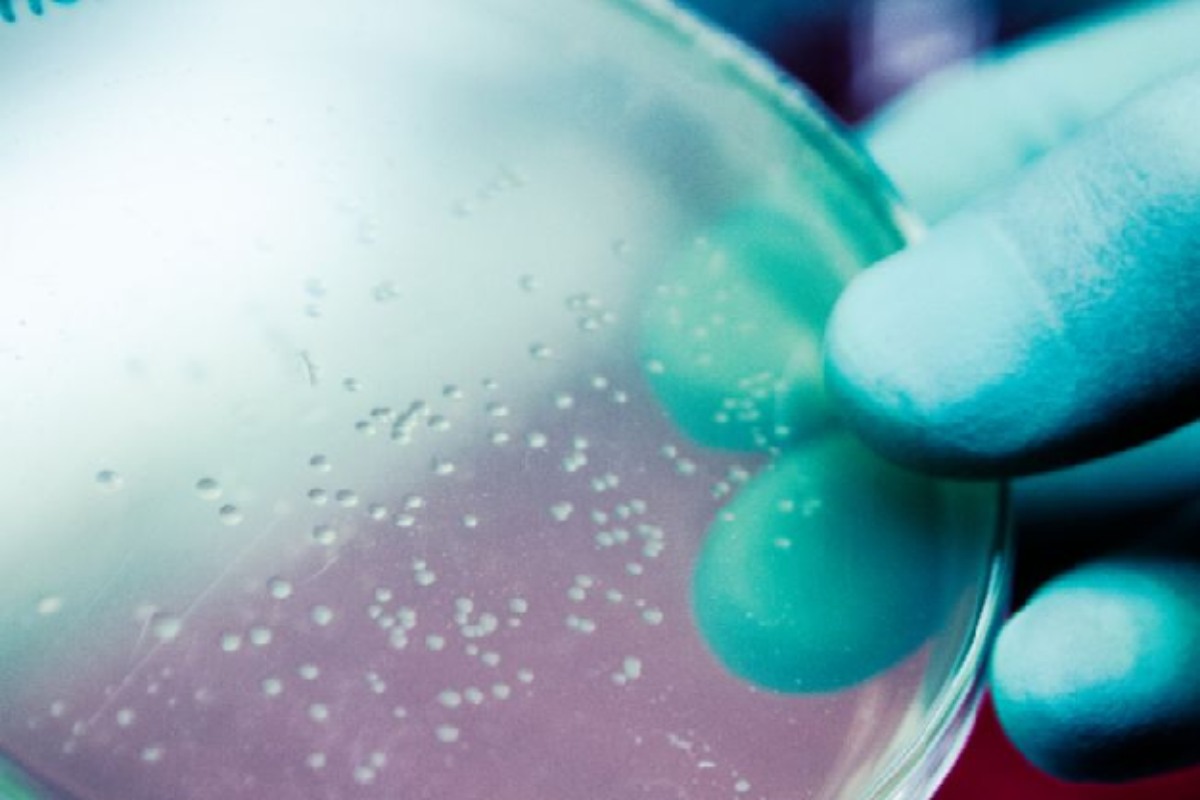

plastic made from bacteria
Global Warming: अमरीका के वैज्ञानिकों ने नए किस्म का प्लास्टिक विकसित किया है, जो एक अवधि बाद अपने आप खत्म हो जाता है। उन्होंने पॉलीयूरीथेन प्लास्टिक में ऐसा बैक्टीरिया मिलाया, जो प्लास्टिक (Plastic) खा जाता है। नेचर कम्यूनिकेशंस में प्रकाशित शोध के मुताबिक प्लास्टिक में मिलाया गया बैक्टीरिया तब तक निष्क्रिय रहता है, जब तक प्लास्टिक इस्तेमाल में रहता है। बैक्टीरिया जब कूड़ा-कर्कट के संपर्क में आता है तो सक्रिय हो जाता है और प्लास्टिक खाने लगता है।
शोध में शामिल कैलिफॉर्निया यूनिवर्सिटी के वैज्ञानिक हान सोल किम का कहना है, हमें उम्मीद है कि यह खोज प्रकृति में प्लास्टिक-प्रदूषण कम करने में मददगार साबित होगी। हमारी प्रक्रिया पदार्थ को ज्यादा खुरदुरा बना देती है। इससे उसका जीवनकाल बढ़ जाता है। जब यह काल पूरा हो जाता है तो हम इसे पर्यावरण से बाहर कर सकते हैं।
नया प्लास्टिक फिलहाल प्रयोगशाला में है। जल्द इसे रोजमर्रा के इस्तेमाल के लिए तैयार किया जा सकता है। इसमें जो बैक्टीरिया मिलाया गया, उसे बैसिलस सबटिलिस कहा जाता है। कुदरती रूप में इसे प्लास्टिक में नहीं मिलाया जा सकता। इसे जेनेटिक इंजीनियरिंग से तैयार करना पड़ता है, ताकि प्लास्टिक बनाने के अत्यधिक तापमान को सहन कर सके।
हर साल 35 करोड़ टन प्लास्टिक का कचरा धरती पर बढ़ रहा है। यह सेहत के लिए खतरा बन चुका है। आमतौर पर प्लास्टिक को खत्म करना मुश्किल है, क्योंकि इसका रासायनिक स्वभाव बेहद जटिल होता है। यह सूक्ष्म मॉलीक्यूल्स से बनता है, जिन्हें मोनोमर कहा जाता है। मोनोमर आपस में जुडक़र मजबूत पॉलीमर बनाते हैं। प्लास्टिक की रीसाइक्लिंग की कोशिशें ज्यादा कामयाब नहीं हो पाई हैं।
Updated on:
02 May 2024 10:15 am
Published on:
02 May 2024 09:53 am
बड़ी खबरें
View Allविदेश
ट्रेंडिंग
